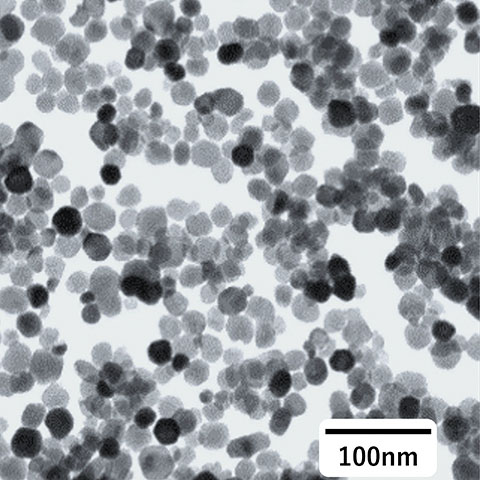

コア技術の一つである「粒子制御技術」を基盤に、ナノ粒子の「合成」から「分散」までを自社内で一貫開発しています。シングルナノ〜数十ナノメートルの微小粒径に特化し、粒子特性を最適化した独自表面処理を施すことで、目的に応じた高機能ナノ分散液の開発を実現。材料設計や塗工プロセスにおける高度なニーズに対応可能です。
特徴
- ナノ粒子合成から分散まで一貫生産
- シングルナノ ~ 数十ナノレベルの小粒径に特化
- 独自表面処理技術により、粒子特性を損なわずに機能を付与
用途例
- 高屈折率材料(ジルコニア、チタン酸バリウム)
- 低屈折率材料(フッ化マグネシウム)
- 高誘電材料(チタン酸バリウム)
- 放熱材料(マグネシア)
製品のラインナップ
ジルコニア / ZrO2


| 粉体物性 | |
|---|---|
| 粒径(nm) | 8 |
| 粒子形状 | 球状 |
| 比表面積(m2/g) | 145 |
| 分散液物性 | |
| 粒子濃度(wt%) | 30 |
| 分散媒 | MEK 等 |
| 特徴 | |
|
高屈折率・高硬度 樹脂への配合で、屈折率 ~1.7を発現することが可能 高透明性(厚膜にも好適) 高分散安定性(例: 40℃、2年以上) ナノインプリント、インクジェットプロセスに対応 |
|
チタン酸バリウム / BaTiO3

| 粉体物性 | |
|---|---|
| 粒径(nm) | 25 |
| 粒子形状 | 球状 |
| 比表面積(m2/g) | 50 |
| 分散液物性 | |
| 粒子濃度(wt%) | 30 |
| 分散媒 | MEK 等 |
| 特徴 | |
|
高屈折率・高耐光性 樹脂への配合で、屈折率 ~1.9を発現することが可能 高透明性・高分散安定性 TiO2代替 ナノインプリント、インクジェットプロセスに対応 |
|
フッ化マグネシウム / MgF2


| 粉体物性 | |
|---|---|
| 粒径(nm) | 20 |
| 粒子形状 | 不定形 |
| 比表面積(m2/g) | 140 |
| 分散液物性 | |
| 粒子濃度(wt%) | 10 |
| 分散媒 | PGME 等 |
| 特徴 | |
|
低屈折率・低誘電率 樹脂への配合で、屈折率 1.4前後を発現することが可能 高透明性・高分散安定性 PFAS代替 |
|
マグネシア / MgO


| 粉体物性 | |
|---|---|
| 粒径(nm) | 35 |
| 粒子形状 | 立方体 |
| 比表面積(m2/g) | 55 |
| 分散液物性 | |
| 粒子濃度(wt%) | 30 |
| 分散媒 | MEK 等 |
| 特徴 | |
|
放熱性・吸湿性 サブフィラーとして、熱伝導パス形成に寄与 高分散安定性 分散液プロセスを経由することでの均一混合により、効率的な熱伝導パス形成が可能 |
|
数値は参考値
サンプルのご相談等につきましては、お問い合わせフォームよりご連絡ください。